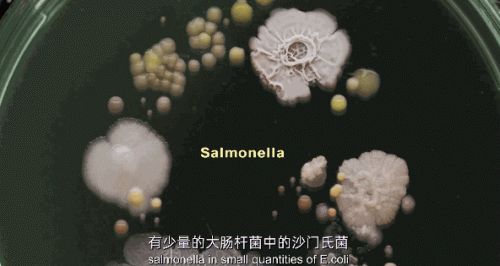

1机3用好物,卡蛙“杀菌机”,综合应对雨后细菌肆虐
近日新闻媒体刊登了一组图片——安徽固镇洪水后人们重返家园,神情茫然,一住户不知所踪,只剩下忠诚的狗狗依然守着门口。照片登出之后立即引起全网广泛热度的关注,网友们纷纷复盘近3个月以来的水害影响。


歙县高考3天特大洪灾,语文数学延迟考试启用备用卷,2207名考生实到不足500人,救援队用水艇、木桶、挖掘机送考生到考场;
三河千年古镇全民动员发起保卫战,动用98辆大巴转移2.8万+名民众;
淮河王家坝16次开闸泄洪,此地是中上游重要泄洪区,村民毅然支持开闸泄洪,油菜花田全部被淹没;
拥有400年历史的黄山屯溪明代镇海桥被这次洪水冲毁,历史部件仍在打捞中……
每一个触目惊心的数字,都昭示着2020年夏季降雨有多么的反常。
正是受此南方连续降雨不见天晴、水患成灾的极端天气影响,刚刚过去的淘宝88会员节,干衣机品类单店购买量达到8000+,而更令人值得注意的是,除螨杀菌机品类的单店成交量更是达到1.3w+。

连续降雨带来的影响,除了引发洪水摧毁经济物和农作物,更可怕的是还会引发一系列难以估计的次生灾害,其中最麻烦的是瘟疫、病毒与细菌滋生。
温州市疾病预防控制中心抽取测试6个样本,其中包括2个月长期潮湿的毛巾,细菌总数高达9.6×106CFU/25c㎡,换算成一条毛巾的面积,那么就有千万个菌落在上面。
这对我们个人与家庭都是看不到的、巨大的威胁。
卡蛙1.5代干衣机pro在应对这些需求上,体现了极高的综合能力,实现“一机三用”,在各po主的实用测评脱颖而出。
“一机三用”就是指:干衣、干鞋、杀菌除螨。PTC发热体打造的速热核心,搭配获得国际大奖的专利风道结构设计,最快能达到1小时速干的效果,搭配不同的支架能快速完成干衣干鞋任务。而1.5代是内置了UV紫外灯,采用巴斯+紫外双重高效杀菌,杀菌率高达98%。

UV是Ultravioletray或Ultravioletradiation的缩写,也就是紫外线,是由德国科学家里特发现的。紫外线可以破坏微生物的遗传物质,使其丧失分裂和复制的能力,新冠病毒就是惧怕紫外线,3月4月全国传统紫外光灯曾一度脱销。
而卡蛙1.5代干衣机采用的是新升级UV灯,照射精准,范围可控,并与高温热风形成高效的UV巴氏杀菌系统,高温+紫外线,对细菌病毒造成“致命打击”。

新升级的UV灯不伤衣、不伤物,所以还可以单独用作其他纺织物的杀菌机——包括床垫、被套、内衣裤、婴童衣物、毛巾浴巾、沙发坐垫等,随时杀菌除螨,不再惧怕阴雨天无阳光,保证家庭生活的每一方面都干透、干爽、干净。
湿润是大部分细菌的温床,其中包括我们常见的大肠杆菌、表皮葡萄球菌、金黄色葡萄球菌等致病菌等,其次,潮湿阴暗的天气也是十分适合螨虫在家居上繁殖生长。
面对雨后的细菌虫螨肆虐,
一定要给自己和家人更好的爱护。
此文内容为企业宣传资讯,仅代表作者个人观点,与本网无关。仅供读者参考,并请自行核实相关内容。如果您发现网站上有侵犯您的知识产权的作品,请与我们取得联系,邮箱: 2058087510@qq.com ,我们会及时修改或删除。
网址:1机3用好物,卡蛙“杀菌机”,综合应对雨后细菌肆虐 https://www.jiaju82.com/news-view-id-715862.html

